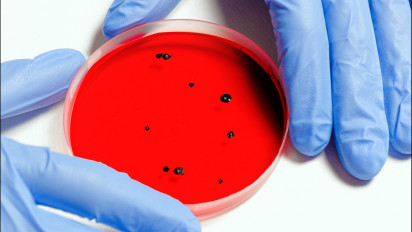
Varian Baru Virus Hendra (HeV) Lebih Mematikan, Begini Gejala-Gejalanya

Varian Baru Virus Hendra (HeV) Lebih Mematikan, Begini Gejala-Gejalanya
- pexels.com
Jakarta – Ditemukan varian baru virus Hendra (HeV) yang jauh lebih mematikan. Para ahli mengungkapkan bahwa virus yang masuk dalam familia Paramyxoviridae di genus Henipavirus ini ditemukan pertama kalinya pada tahun 1994.
Tepatnya di Hendra, Brisbane, Australia, virus Hendra ini terdeteksi bahwa berasal dari spesimen yang dihasilkan dari penyakit neurologis dan pernapasan yang menyerang manusia dan kuda.
Menurut penelitian, inang dari varian virus baru ini adalah kelelawar pemakan buah. Kelelawar pemakan buah yang terjangkit virus Hendra (HeV) dapat menularkannya ke kuda melalui buah yang dimakan oleh kelelawar. Selain itu, kuda yang terjangkit dapat lanjut menularkan virus ini ke manusia melalui kontak cairan tubuh kuda seperti cairan hidung atau darah kuda.
Apakah Virus Hendra Dapat Menular ke Sesama Manusia?
Sampai saat ini hingga artikel ditayangkan, belum ada laporan kasus terkait penularan virus Hendra (HeV) yang terjadi antar manusia ataupun antar kelelawar ke manusia.
Dikutip dari keterangan Prof. Zubairi Djoerban, Ketua Penanganan Satgas Covid-19 IDI di akun Instagramnya (@profesorzubairi) pada Sabtu (21/05/2022) dikatakan bahwa virus varian baru ini hanya ditularkan ke manusia jika terkena kontak dengan kuda yang terkontaminasi virus HeV.
¨Hingga saat ini belum ada bukti penyebaran Hendra dari manusia ke manusia, maupun kelelawar ke manusia. Manusia hanya tertular dari kuda,¨ tulis keterangan Prof. Zubairi Djoerban.
Gejala-Gejala Jika Terjangkit Virus Hendra
Jika kita terjangkit virus Hendra (HeV), tentunya ada beberapa gejala yang menjadi penanda bahwa kita harus segera mengunjungi dokter untuk melakukan pengobatan. Oleh karena itu, selalu perhatikan kondisi tubuh Anda jika merasakan gejala-gejala berikut ini:
- Batuk
- Sakit kepala
- Demam
- Kelelahan
- Sakit tenggorokan
Adapun gejala lainnya jika penyakit sudah akut, di antaranya:
- Pendarahan
- Radang selaput otak
- Kejang-kejang
- Edema Paru
- Koma
Sumber lain juga mengatakan bahwa gejala lain dari virus Hendra adalah rasa kantuk tidak biasa, saluran pernapasan terganggu dan efek linglung. Jika Anda merasakan berbagai gejala di atas, segeralah periksakan diri Anda ke dokter untuk mendapatkan penanganan lebih lanjut. (rka)

Load more